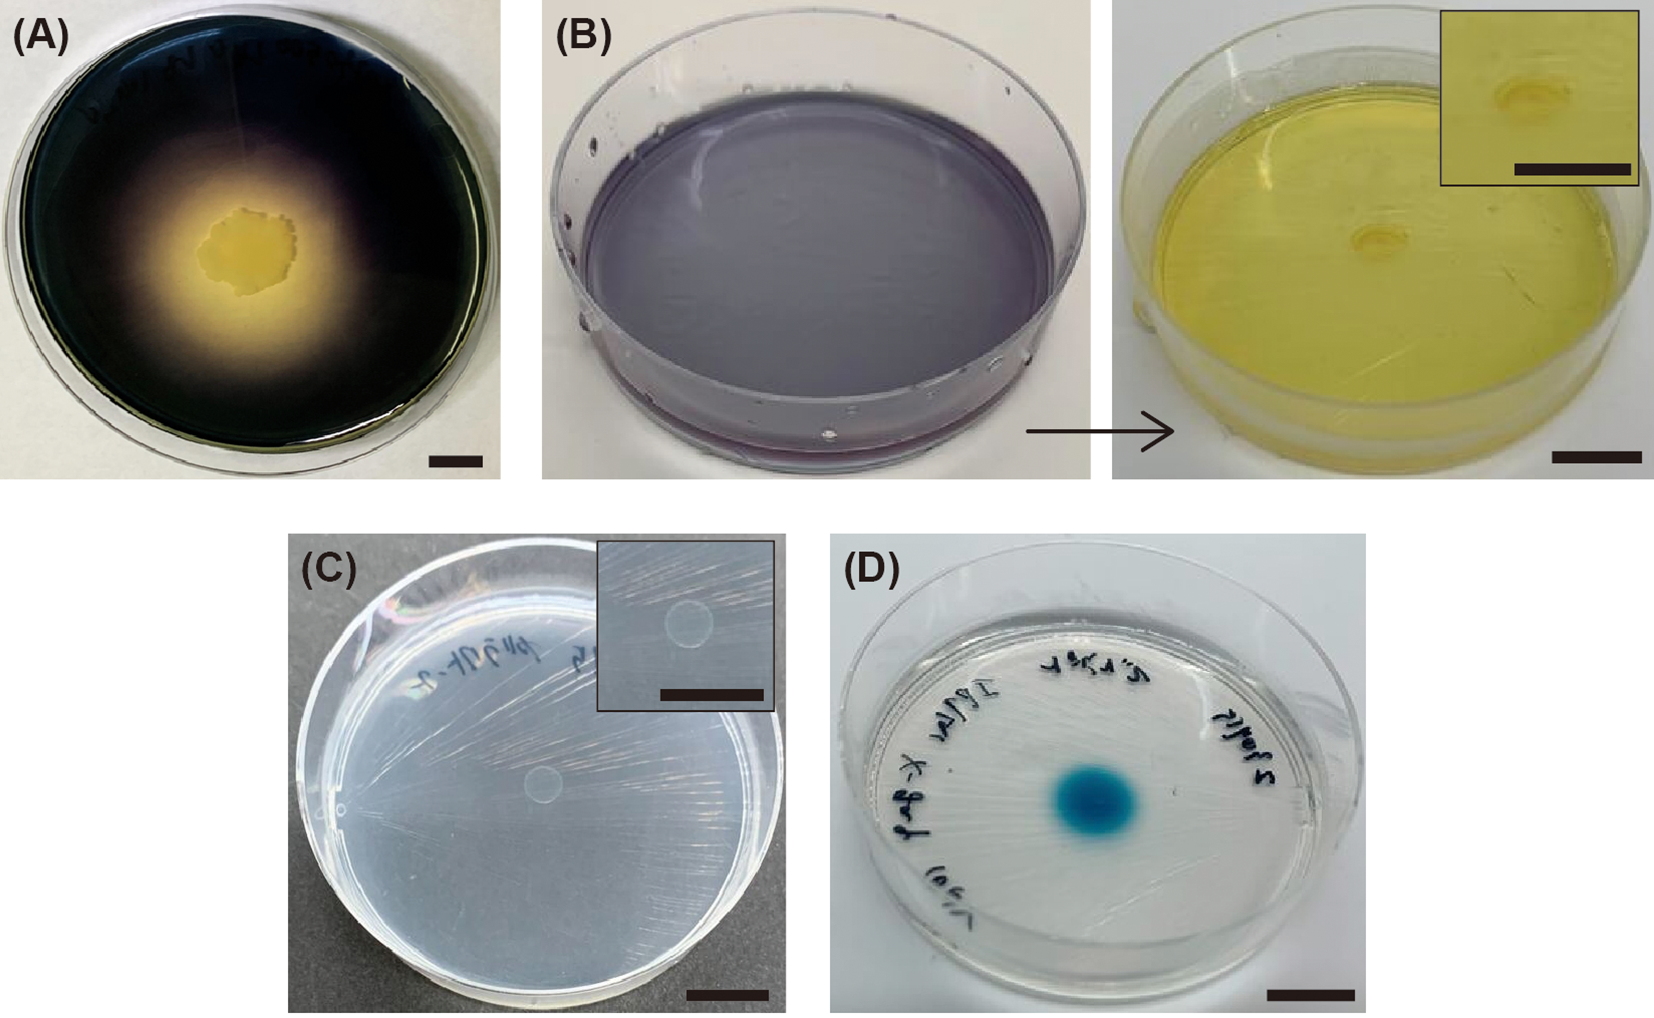

Abstract
Enhancing fish growth and bolstering immune responses to diseases are of paramount concern in fish aquaculture. The use of probiotics has emerged as a promising strategy for addressing these challenges. The aim of this study was to investigate the characteristics (salinity tolerance, starch-assimilating ability, organic acid production, β-galactosidase activity) of Heyndrickxia coagulans SANK70258 and its probiotic effects on red sea bream (Pagrus major). Our results indicate that H. coagulans SANK70258 exhibits a high salinity tolerance and thrives as a probiotic in marine environments. Moreover, its starch assimilation capability, organic acid production, and β-galactosidase activities suggest that it might play a role in enhancing the host’s immune system. Over the 63-day experimental period, supplementation with H. coagulans SANK70258 significantly increased the survival rate of red sea bream compared with that of the experimental control group (vehicle starch for the probiotic) after the final experimental day, as determined by Kaplan–Meier analysis (log-rank test, p = 0.0228). Furthermore, supplementation affected the body length and weight of fish, but it did not influence digestive enzyme activities. The goblet cell abundance in the intestinal tract of fish supplemented with H. coagulans SANK70258 was significantly higher than that in the experimental control group (Welch’s t-test, p = 0.03742). These results suggest that H. coagulans SANK70258 is a promising probiotic for enhancing marine fish aquaculture production.
1 Introduction
In fish aquaculture, the advancement of techniques to promote fish growth and activate immune responses against diseases is of paramount importance and is driven by the increasing demand for aquatic products. The use of probiotics has emerged as an effective strategy to address this challenge, as reported in previous studies. For example, a report demonstrated that Lactococcus lactis could enhance growth and activate innate immune responses in olive flounder (Paralichthys olivaceus; Kim et al., 2013). Similarly, red sea bream (Pagrus major) fed diets supplemented with a mixture of Lactobacillus rhamnosus and L. lactis exhibit a remarkable increase in weight gain of up to 140% after 56 days of feeding (Dawood et al., 2016). These probiotic bacteria have significant effects on the innate immune system of red sea bream. The efficacy of probiotics has also been demonstrated in other aquatic organisms, particularly freshwater fish and shrimp (El-Saadony et al., 2021). Given the existence of the opportunistic pathogens such as Aeromonas hydrophila, it is crucial to develop effective solutions (Das et al., 2008; Semwal et al., 2023).
The effective use of probiotics in fish involves ensuring that they reach the intestines alive. However, probiotics must also withstand the challenges of changing environments. For example, in gilthead sea bream (Sparus aurata), pH levels can vary widely from 2.5 to 7.9 across different gut regions and/or in response to feeding schedules (Deguara et al., 2003). Heat treatment is often required during feed production to eliminate opportunistic microbes. These intolerable stresses can be critical for many probiotics, including major probiotics such as lactic acid bacteria (De Angelis and Gobbetti, 2004). Furthermore, in marine environments, salinity levels are higher than those in other environments, which poses additional stress when applying probiotics.
The introduction of spore-forming bacteria is a promising strategy to address these challenges. One example is Heyndrickxia coagulans, which is a lactic acid bacterium formerly classified as Bacillus coagulans or Weizmannia coagulans. It can form spores, which allow it to survive and thrive in diverse ecological niches. Previous studies demonstrated the probiotic effects of H. coagulans SANK70258 on broiler chicks. These effects include preventing diseases as an alternative to antimicrobials and increasing the body weight of broiler chicks (Aida et al., 2022). In addition, the supplementation of H. coagulans to broiler chicks leads to a balanced intestinal microbiota composition and enhanced intestinal function (Aida et al., 2023). Based on these results, H. coagulans may be a promising probiotic (Zhang S, et al., 2024) for fish aquaculture.
Several researchers have investigated the potential of H. coagulans as a probiotic in fish aquaculture and have demonstrated improvements in the growth performance and survival rates. However, most studies were focused on freshwater fish species (Wang, 2011; Wang et al., 2016; Xu et al., 2014; Yu et al., 2016), leaving a research gap with respect to marine species. For instance, positive effects of H. coagulans supplementation have been observed in the growth performance and potential disease resistance of turbot (Scophthalmus maximus; Zhao et al., 2023) and in the disease resistance to pathogenic Vibrio of grouper (Epinephelus coioides; Pan et al., 2013), both marine fish species. However, research on the probiotic potential of H. coagulans, particularly in marine aquaculture, is limited.
In this study, we investigated the potential positive effects of H. coagulans SANK70258 on red sea bream (P. major) for the first time. We examined the growth performance, survival rate, digestive enzyme activity, and histological observations of the intestinal tract of red sea bream to assess the probiotic effects of H. coagulans SANK70258, which was provided by the Mitsubishi Chemical Corporation. Our findings will help confirm a promising probiotic for enhancing marine fish aquaculture production.
2 Materials and methods
2.1 Physiological characteristics of H. coagulans SANK70258
We investigated the NaCl tolerance of H. coagulans SANK70258 to evaluate its potential growth and survival in marine environments. The strain was isolated on Luria-Bertani (LB) agar (10 g/L Bacto tryptone, 5 g/L Bacto yeast extract, 10 g/L NaCl, and 15 g/L Bacto agar in distilled water), inoculated into LB broth containing 1%–6% NaCl and incubated at 37°C under shaking at 120 rpm for 10 days. Growth was monitored by measuring the optical density at 660 nm using a 518R digital colorimeter (TAITEC Corporation, Saitama, Japan).
Starch assimilation was assessed using LB agar containing 1% (w/v) starch. Organic acid production was estimated using agar supplemented with 1% (w/v) starch as the sole carbon source, 8 g/L K2HPO4, and 0.0025% bromocresol purple. Galactose and lactose assimilation assays were conducted on galactose-sole carbon source agar (10 g/L galactose, 8 g/L K2HPO4, and 15 g/L Bacto agar in distilled water) and starch-sole carbon source agar supplemented with Isopropyl β-D-1-thiogalactopyranoside (IPTG) and X-gal solution, respectively. H. coagulans SANK70258 was inoculated onto each agar plate and incubated at 37°C for one to five days. Starch assimilation was confirmed by the formation of a clear halo around the bacterial colony after the application of an iodine solution (5 mM I2, 5 mM KI). Organic acid production is indicated by the development of a yellow zone surrounding the colony. Galactose assimilation was determined by colony formation on galactose-containing agar plates, whereas lactose assimilation was confirmed by the formation of blue colonies on IPTG/X-gal-containing agar plates.
2.2 Design of feeding experiment
The experiments were approved by the Animal Welfare Committee of the Aquaculture Research Institute of Kindai University and were conducted in accordance with the Guidelines for Animal Experimentation at the Aquaculture Research Institute of Kindai University (ARIKU-AEC-2022-64).
The experiment was conducted at the Aquaculture Research Institute, Amami Station, Kindai University, for nine weeks (Supplementary Figure 1). We utilized 4,800 red sea bream juveniles (P. major) sourced from the production line on the 42nd day after hatching. In particular, 800 juveniles were placed in each of the six 1-ton square tanks and acclimatized for three days to a new environment. Throughout the acclimation period, the juveniles in each tank were provided with the same commercial feed used in the production line to ensure that they were adequately fed. On the third day of acclimation, the juveniles were fed only in the morning, and then feeding was suspended until the start of the experiment began the next day to clearly observe the effects of H. coagulans SANK70258 without interference from the feed given during acclimation. Two experimental groups, one treated with H. coagulans SANK70258 (HC group) and one treated with excipient starch for H. coagulans SANK70258 (ST group), were assigned to two tanks each. The ST group serves as an experimental control for the HC group because H. coagulans SANK70258 is delivered with starch as an excipient, and the effect of starch alone must be considered. In addition, to ensure the baseline health of the fish, an untreated control group consisting of two tanks was established. The fish were reared using the same methods as those used in the production line, with ultraviolet (UV)-irradiated sand-filtered seawater (UV-irradiated seawater) at a daily water replacement rate ranging from 1,000% to 3,100% depending on their growth.
In the HC group, H. coagulans SANK70258 was applied to the same commercial pellet used in the production line (Supplementary Table 1). The ST group received starch pellets instead of H. coagulans SANK70258. Commercial pellets of either H. coagulans SANK70258 or starch (10% feed weight) and a binder E&C Coat (1% feed weight, VPS235, Meiji Seika Pharma Co., Ltd, Tokyo, Japan) were thoroughly mixed in a plastic bottle (Supplementary Materials and Methods). The concentration of H. coagulans SANK70258 was maintained at 108 colony-forming units (cfus/g feed), a level sufficient to improve the health outcomes of broiler chicks as reported in previous studies (Aida et al., 2022, 2023). Experimental feeds were freshly prepared each day. The feeding amount was adjusted based on the growth of the fish (5%–10% of body weight; Supplementary Table 1) and delivered six to eight times daily using an automatic feeder (DF-100MS, MATSUI Corporation, Tokyo, Japan). Satiation feeding was performed to ensure no visually detectable residual feed. Throughout the experiment, daily siphoning was performed to remove excrement from the bottom of the tank and the tank was cleaned with a sponge one to three times weekly. Dead fish were inspected and removed four times daily, twice in the morning and twice in the afternoon. All operations were conducted with gloves and the breeding equipment dedicated to each experimental group was regularly sterilized with chlorine.
2.3 Sample collection
Throughout the experiment, we monitored environmental characteristics including the water temperature, salinity, pH, dissolved oxygen (DO), and abundance of Vibrio bacteria (Supplementary Table 2). Measurements were conducted daily using the following instruments: YSI ProSolo DO meter (Xylem, Kanagawa, Japan) for water temperature and DO, TPX-999 pH meter (Toko Chemical Laboratories Co. Ltd., Tokyo, Japan) for pH, and RAWS-100 refractometer (AS ONE Corporation, Osaka, Japan) for salinity. For Vibrio bacteria estimation, 1 mL subsamples of rearing water were collected every 14 days.
Twenty fish from each tank were collected at regular intervals and immediately ice-killed to measure the growth performance. Of these, samples were taken from five fish for digestive enzymes and from three fish for intestinal tract tissue (Supplementary Figure 1). The surfaces of the collected fish were washed 10 times with 150 mL of UV-irradiated seawater to remove bacteria from the surrounding rearing water. The fork length, standard length, and body weight of the fish were measured using a CD-20 caliper (Mitsutoyo Corporation, Kanagawa, Japan) and AUX220 analytical balance (Shimadzu Corporation, Kyoto, Japan). After measuring the growth performance, the intestinal tract was promptly removed from each fish using sterilized dissecting scissors. Subsequently, the fish were placed into a 2 mL tube for the measurement of digestive enzymes and stored at –80°C (n = 5). The intestines of the remaining fish were placed into separate 2 mL tubes containing 2 mL of Bouin’s solution (5% acetic acid, 9% formaldehyde, and 0.9% picric acid) and stored at 4°C (n = 3).
2.4 Vibrio bacteria estimation
To estimate Vibrio bacteria, we utilized two Vibrio-selective plates: thiosulfate-citrate-bile saccharose (TCBS) agar (CM0333, Oxoid Limited, Adelaide, Australia) and CHROMagar Vibrio agar (VB912, CHROMagar). Vibrio bacteria were estimated using the drop plate method with a 10-fold serial dilution to 10−5 with autoclaved seawater. Five microliters of the serially diluted samples were dropped (six drops per dilution) onto both agar plates and incubated at room temperature. Colonies that formed within 24 h were counted as Vibrio bacteria using a stereomicroscope. A colony was defined as a single Vibrio cell and represented as cfu.
2.5 Measurement of digestive enzymes
In this study, we assessed the activities of acid and basic proteases, amylase and lipase, as digestive enzymes in intestinal tract samples. Initially, the intestinal tract samples were crushed in 1 mL of Milli-Q water using a Micro Smash MS-100 bead beater (TOMY SEIKO Co. Ltd., Tokyo, Japan). After centrifugation, the supernatant was collected and used as the crude enzyme extract. The crude extract was diluted tenfold with Milli-Q water and used for further analyses.
The total protein content of the crude extract was determined using the Bradford Protein Assay Kit (Takara Bio Inc., Shiga, Japan) according to the manufacturer’s protocol. After treatment, the absorbance (wavelength 595 nm) was measured with an SH-9000Lab microplate reader (Hitachi High-Tech Corporation, Tokyo, Japan), dilution series of bovine serum albumin solution for calibration, and Milli-Q water as a control. The protein content was used to standardize the digestive enzymatic activities per unit protein. Acid and basal protease activities were assessed using a modified casein-folin method (Oda and Murao, 1974). Substrate solutions containing 4.0% casein were prepared by adding 100 mM HCl-lactic acid buffer (pH 3.0) and 100 mM NaOH-boric acid buffer (pH 9.0) to measure acid and basal protease activities, respectively. After the treatment, the absorbance (wavelength 600 nm) was measured with an SH-9000Lab microplate reader using a dilution series of tyrosine solution for calibration. One unit of protease activity was defined as the production rate of 1 µmol tyrosine per minute. The amylase activity was assessed using the method reported by Xiao et al. (2006), with slight microplate modifications. After treatment, the absorbance (wavelength 580 nm) was measured with an SH-9000Lab microplate reader and a dilution series of starch solutions for calibration. One unit of amylase activity was defined as the degradation rate of 1 mg of starch per min. The lipase activity was assessed using a Lipase Kit S (BS-92101, Sumitomo Bakelite Co., Ltd., Tokyo, Japan) according to the manufacturer’s protocol, with slight microplate modifications. After treatment, the absorbance (wavelength 412 nm) was measured using an SH-9000Lab microplate reader. The lipase activity was calculated in international units per liter (IU/L) using the following equation:
where ODs and ODc represent the absorbance of the sample and control, respectively, and the factors 0.001 and 0.147 are conversion factors for BALB units and international units, respectively.
2.6 Histological observation of the intestinal tract
Bouin-fixed samples were dehydrated in a series of alcohols, clarified using Fast Solve (FALMA Co., Tokyo, Japan), and subsequently embedded in paraffin wax. Paraffin blocks targeting the middle part of the intestinal tract were sectioned into 7 µm-thick slices using a rotary microtome (RM2235, Leica Biosystems GmbH, Nußloch, Germany). The sections were then subjected to hematoxylin and eosin (HE) staining using standard procedures. The number of goblet cells was visually counted within a unit gut area, which was measured using ImageJ 1.54 g.
2.7 Statistical analyses
Statistical analyses were performed using R software version 4.2.2 (Team, R. C, 2022). The survival probability was estimated using the Kaplan-Meier method and significance was tested with the log-rank test using the Kaplan-Meier “survival” package (Therneau, 2023). The survival curve was visualized using the “survminer” package (Kassambara et al., 2021). Welch’s t-test was performed to assess differences in growth parameters, digestive enzymes, and goblet cells between groups and/or experimental days. Statistical significance was set at p < 0.05.
3 Results
3.1 Physiological characteristics of H. coagulans SANK70258
H. coagulans SANK70258 is tolerant to high NaCl concentrations, with a growth rate of up to 6% (Figure 1). Furthermore, sufficient growth was observed within 24 h at NaCl concentrations ranging between 1% and 4%. This was also supported by the relative absorbance at 24 h or the time of maximum absorbance at each NaCl concentration. H. coagulans SANK70258 assimilated starch as its sole carbon source for growth, producing organic acids as byproducts (Figure 2). Furthermore, it exhibited the ability to grow on agar containing galactose as the sole carbon source and to express β-galactosidase activity on starch agar supplemented with IPTG/X-gal.
Figure 1

Growth characteristics of H. coagulans SANK70258 in NaCl-containing LB media. (A) Growth curves over 24 hours and (B) 10-day incubation periods, and (C) relative absorbance after 24 hours or at the time of maximum absorbance for each NaCl concentration.
Figure 2
Characteristics of H. coagulans SANK70258 related to amylase, organic acid, galactose, and β-galactosidase. (A) Amylase ability using starch-LB agar, (B) Organic acid production using starch-sole carbon source agar supplemented with bromocresol purple, (C) Galactose utilization ability using galactose-sole carbon source agar, and (D) β-galactosidase ability using starch-sole carbon source agar supplemented with IPTG and X-gal. The scale bars in the photographs represent 10 mm.
3.2 Environmental characteristics in the feeding experiment
Environmental characteristics, including the water temperature, salinity, dissolved oxygen, and pH, remained stable across all tanks in both the HC and ST groups (Supplementary Table 3). Throughout the experiment, the water temperature and salinity ranged from 20.30 to 24.00°C and 32‰ to 36‰, respectively, falling within the typical range for production in this aquaculture area. In addition, the dissolved oxygen concentration (7.13–8.69 mg/L) and pH (8.36–8.71) measured throughout the experiment indicated sufficient and suitable conditions for red sea bream growth. Colony variation patterns observed on TCBS and CHROMagar Vibrio agar were nearly identical throughout the experiment (Supplementary Figure 2). The colony abundances in both the HC and ST groups increased to a peak of ~2.5 × 104 cfus/mL on days 14 or 28. Following this peak, the abundance decreased to ~1.0 × 103 cfus/mL.
3.3 Effect of H. coagulans SANK70258 on the growth performance of red sea bream
The growth performance observed in the untreated control group using standard fish production methods at the aquaculture site indicated normal growth of red sea bream, confirming the suitability of the experimental fish for this study (Supplementary Figure 3).
The survival plot generated by the Kaplan-Meier analysis is shown in Figure 3. In the ST group, fish mortality began immediately after the start of the experiment, with an increased rate of decline observed after day 40. In contrast, the mortality rate in the HC group was significantly lower than that in the ST group (log-rank test, p = 0.0228). A few deaths occurred immediately after the start of the experiment, with the mortality increasing after 40 days.
Figure 3

Survival rates estimated by the Kaplan-Meier method for each group throughout the experiment. Survival curves are shown with 95% confidence intervals. P values were calculated using the log-rank test to compare survival distributions between groups.
During the experiment, the body lengths and weights of fish in the HC group were occasionally significantly higher than those in the ST group (Figure 4). The median body length of fish in the HC and ST groups was 29.9 mm (interquartile range, IQR 27.4–31.5 mm) and 29.4 mm (IQR 27.8–30.8 mm), respectively, on the first day (day 0) and 91.0 mm (IQR 87.9–93.1 mm) and 91.8 mm (IQR 90.2–93.8 mm), respectively, on the last day (day 63). No significant differences were observed in the body lengths of fish in the HC and ST groups on the last day (day 63; Welch’s t-test, p = 0.0886). A similar trend was observed for the fish body weight. The median body weights of fish in the HC and ST groups were 0.711 g (IQR 0.589–0.850 g) and 0.697 g (IQR 0.618–0.805 g), respectively, on the first day (day 0) and 26.499 g (IQR 24.072–29.151 g) and 27.025 g (IQR 25.506–29.179 g), respectively, on the last day (day 63). Similar to the body length, no significant difference was observed in the body weight of fish between the HC and ST groups on the last day (day 63; Welch’s t-test, p = 0.412). Other indices of the fish growth performance, such as weight gain, specific growth rate, feed intake, and feed efficiency, did not differ between the HC and ST groups (Table 1). Similarly, digestive enzymes, such as acid and basal proteases, amylase, and lipase, showed no significant differences between the HC and ST groups (Figure 5; Welch’s t-test, p > 0.05).
Figure 4

Growth performance of fish in each group throughout the experiment. (A) Fish body length, and (B) Fish body weight. An asterisk denotes a significant difference (Welch’s t-test, p < 0.05).
Table 1
| Growth index | HC group | ST group | ||||
|---|---|---|---|---|---|---|
| Tank 1 | Tank 2 | Average | Tank 1 | Tank 2 | Average | |
| WG (g) | 25.55 | 27.45 | 26.50 | 25.87 | 26.52 | 26.20 |
| WG (%) | 3750.6 | 3792.1 | 3771.4 | 3596.7 | 3891.5 | 3744.1 |
| SGR (% day−1) | 5.79 | 5.81 | 5.80 | 5.73 | 5.85 | 5.79 |
| FI (g fish−1) | 24.79 | 24.82 | 24.80 | 25.16 | 24.92 | 25.04 |
| FE | 1.03 | 1.11 | 1.07 | 1.03 | 1.06 | 1.05 |
Effect of H. coagulans SANK 70258 on the fish growth performance on the last day of the experiment (day 63).
Weight gain (WG) (g) = final body weight (g) - initial body weight (g).
WG (%) = (final body weight (g) - initial body weight (g))/initial body weight (g) × 100.
Specific growth rate (SGR) = (ln(final weight (g)) - ln(initial weight (g))) × 100/63 days.
Feed intake (FI) = Σ(given feed/fish in each day).
Feed efficiency (FE) = WG (g)/FI.
Figure 5

Digestive enzymatic activities of fish in each group throughout the experiment. (A) Acid protease. (B) Basal protease. (C) Amylase. (D) Lipase.
On the last day of the experiment (day 63), the abundance of goblet cells in the fish intestinal tract was significantly higher in the HC group than in the ST group (Welch’s t-test, p = 0.03742, Figure 6, Table 2). Notably, no significant difference was observed in the cross-sectional area between the two groups (Welch’s t-test, p = 0.3381). Specifically, the goblet cell densities per cross-sectional area were 355.8 ± 71.3 and 182.8 ± 29.3 cells/mm2 in the HC and ST groups, respectively.
Figure 6

Histological observations of fish intestinal tracts on the last day of the experiment, highlighting the differences in the goblet cell abundance between the ST (A–C) and HC (D–F) groups. Arrows indicate representative goblet cells (specialized mucus-producing cells). The scale bars in the photographs represent 200 µm.
Table 2
| Group | Cross-sectional area (mm2)a |
p valueb | Goblet cells (cells/mm2)a |
p valueb |
|---|---|---|---|---|
| HC | 0.924 ± 0.140 | 0.3381 | 355.8 ± 71.3 | 0.03742 |
| ST | 1.084 ± 0.209 | 182.8 ± 29.3 |
Goblet cells in the intestinal tract of fish in the HC and ST groups on the last day of the experiment (day 63).
aaverage ± standard deviation; bWelch’s t-test (n = 3)
4 Discussion
To the best of our knowledge, this is the first report demonstrating the probiotic effects of H. coagulans in red sea bream aquaculture. Previous studies were primarily focused on the use of probiotics in aquaculture, addressing various purposes such as the improvement of the water quality, pathogen inhibition, growth promotion, enhancement of nutrient digestion ability, stress tolerance, and reproductive performance of the host (El-Saadony et al., 2021). They were mostly focused on freshwater fish and shrimp and thus little is known about the effects of probiotics on marine fish. For example, in olive flounder (P. olivaceus), the probiotic L. lactis enhanced growth and activates innate immune responses (Kim et al., 2013). In red seabream (P. major), a mixture of Lb. rhamnosus and L. lactis increased the fish weight gain by up to 140% and activated the immune system after 56 days of feeding (Dawood et al., 2016). We explored the potential of H. coagulans SANK70258, specifically for red sea bream aquaculture, because previous research demonstrated its effect on broiler chicks (Aida et al., 2022, 2023) but its influence on fish remains unclear (Zhao et al., 2023). We conducted a series of experiments to evaluate the effects of H. coagulans SANK70258 on the growth performance, survival rate, digestive enzyme activity, and histological observations of the intestinal tract of red sea bream.
Our results demonstrate that H. coagulans SANK70258 exhibits a high salinity tolerance (Figure 1), enabling its successful adaptation to marine environments. The ability of probiotics to thrive in such conditions is pivotal for their application in marine fish aquaculture, facilitating the realization of their full potential. In addition, our results reveal that H. coagulans SANK70258 possesses starch-assimilating capabilities (Figure 2A), which is consistent with the results of a previous study demonstrating amylase production by a different strain of H. coagulans (Midhun et al., 2018). Considering that many marine fish, including red sea bream, lack the ability to degrade starch (Jeong et al., 1991), the starch-assimilating capacity of H. coagulans SANK70258 presents a solution to the challenge of obtaining carbohydrate sources from marine fish diets. Furthermore, our results indicate that H. coagulans SANK70258 produces organic acids (Figure 2B) and likely utilizes the Leloir pathway (Figures 2C, D), which is related to the activation of the host immune system (Audy et al., 2010; Morita et al., 2019). The results of studies using human fecal cultures showed that H. coagulans SANK70258 promotes butyrate production in the gut microbiota in concert with lactate-utilizing butyrate-producing bacteria, such as Lachnospiraceae, supporting our hypothesis (Duncan et al., 2004; Esquivel-Elizondo et al., 2017; Sasaki et al., 2020). In addition, H. coagulans SANK70258 did not induce an increase in Vibrio bacteria in the rearing water (Supplementary Figure 2), suggesting its safety as a probiotic. Collectively, these results highlight the effectiveness of H. coagulans SANK70258 as a probiotic in marine fish.
This study demonstrates that H. coagulans SANK70258 improves the survival rate of fish (Figure 3). Although research on H. coagulans (formerly classified as B. coagulans) remains limited, existing studies demonstrated its promising effects as a probiotic. For example, a study on marine fish indicated that the oral administration of H. coagulans to groupers infected with V. vulnificus significantly improved the grouper survival rate (Zhao et al., 2023). Similarly, several reports on freshwater fish suggested that H. coagulans promotes the growth performance and immune responses (Xu et al., 2014) and enhances the resistance to pathogenic infection (Midhun et al., 2018; Pan et al., 2013; Yu et al., 2016). In contrast, while the enhancement of the survival rate in this study aligns with previous results, H. coagulans increased the body length and weight only during the middle of our experiment (Figure 4). The absence of notable promotional effects may be attributed to the mature gut microbiota of the fish used in this experiment. A previous study demonstrated that late juvenile bluefin tuna exhibit specific and stable gut microbiota during commercial pellet feeding (Taniguchi et al., 2022). Notable differences in the body length and weight of fish between the HC and ST groups were not detected in this experiment, likely because of the established gut microbiota, suggesting limited opportunities for the introduction of probiotics. It is now recognized that fish gut microbiota influences the overall health of the fish (Butt and Volkoff, 2019; Bharathi Rathinam et al., 2024). Although the resident microbiota can be difficult to alter, probiotics are known to modulate gut microbial populations through a synbiotic function (Ringø et al., 2010; Zhang Z, et al., 2024), even without becoming a permanent part of the stable community. This modulation could still contribute to the overall health and performance of the fish, despite the lack of significant differences in growth parameters. Therefore, the introduction of probiotics at an earlier stage of fish larval development could yield more pronounced and effective results. Additionally, it has been speculated that the dosage of H. coagulans SANK70258 may have been low or that feed compatibility issues could have affected the results, but further studies are needed to verify this hypothesis.
There is a limitation in this study. H. coagulans SANK70258 has been shown to improve various phenotypes by activating the immune status of the intestinal tract as well as the whole body, triggering a modifying effect on the intestinal microbiota. In line with these reports, the observed improvement in the survival rate of P. major in this study may be mediated by the effect of H. coagulans SANK70258 on the intestinal microbiota; however, we did not perform an analysis of the intestinal microbiota. In the future, we plan to analyze the intestinal microbiota and investigate the relationship between the improved survival rate of P. major and changes in intestinal microbiota composition induced by H. coagulans SANK70258.
In this study, we observed an increase in goblet cells (Figure 6 and Table 2), which are responsible for mucus production, suggesting the potential stimulation of mucus production in the fish intestinal tract by H. coagulans SANK70258. Goblet cells produce mucin, high molecular glycoprotein that physically protects mucosal surfaces from external stimuli and plays a central role in intestinal barrier function, preventing pathogens and other organisms from entering the body. In other words, goblet cells play a crucial role in the maintenance of intestinal homeostasis and act as gatekeepers of the mucosal immune system (Birchenough et al., 2015). It is also known that goblet cells increase their activity when exposed to probiotic intervention (Liu et al., 2020). The results of previous studies showed varying effects of probiotics on the goblet cell abundance in different fish species. For example, supplementation with a mixture of three probiotics (Acetobacter spp., Lactobacillus spp., and Pseudomonas spp.) increased the goblet cell abundance in turbot (Li et al., 2019), whereas supplementation with the probiotic B. subtilis decreased the goblet cell abundance in gilthead sea bream (Cerezuela et al., 2013). Probiotics have dual effects on the goblet cells of the host fish, as observed in freshwater fish as well (Ramos et al., 2015, 2017). These results suggest that the effects of probiotics on goblet cells and the associated immune system may not be universal but may vary depending on the fish species. A previous report on H. coagulans suggested that its combination with Lb. plantarum may increase the number of goblet cells in zebrafish (Wang et al., 2016). In vivo and in vitro studies showed that H. coagulans SANK70258 strongly enhances the immune function in the intestinal tract and peripheral tissues (Ikeda et al., 2023). In addition, it has been reported that when H. coagulans SANK70258 is ingested by individuals prone to cold-like symptoms, it alleviates these symptoms and contributes to the activation of not only the local intestinal tract but also systemic immunity (Aida et al., 2024). Enhancement of gut immune function by H. coagulans SANK70258 through modification of the gut microbiota has also been reported to improve gut barrier function in pathogenic protozoan-infected animals, suggesting a species-universal immune function-enhancing effect of H. coagulans SANK70258 (Aida et al., 2022, 2023). The same study on broilers showed that the gene expression level of IL-22, a cytokine involved in goblet cell activity, was increased by H. coagulans SANK70258. Furthermore, it has been reported that treatment of Salmonella-infected broilers with H. coagulans significantly increased the number of goblet cells and the expression level of the Muc2 gene, which is involved in mucin production, correlating with an improvement in disease status (Xie et al., 2022). This is consistent with the results of this study. These reports suggest that the increase in goblet cells observed with H. coagulans SANK70258 administration in this study is the result of increased IL-22 production and that this change may also contribute to mucin production. In previous studies, the effect of H. coagulans on humans, mice, and broilers was evaluated, whereas this study investigated its effect on the activation of immune cells in fish. Our results contribute to the understanding of complex interactions between probiotics and goblet cells in fish intestines. Although our study highlights the potential stimulatory effect of H. coagulans on the goblet cell abundance, contrasting observations in other fish species and/or probiotics underscore the need for further research to elucidate probiotic–goblet cell interactions affecting fish intestinal health.
5 Conclusion
Supplementation of H. coagulans SANK70258 to red sea bream resulted in improved survival rates and an increase in goblet cells in the fish intestinal tract. The high salinity tolerance of H. coagulans SANK70258 suggests its ability to thrive in marine environments, potentially maximizing its benefits in the intestines of marine fish. The strain’s abilities of starch assimilation, organic acid production, and β-galactosidase likely contribute to the observed improvements in the survival rates and goblet cell abundance. However, this probiotic showed no discernible effects on the final body length, weight, or digestive enzymes. To comprehend the benefits of H. coagulans SANK70258, it may be beneficial to introduce probiotics earlier, that is, prior to the establishment of intestinal microbiota. However, further research is required to explore this hypothesis. In conclusion, H. coagulans SANK70258 holds promise in enhancing the production efficiency of marine fish aquaculture.
Statements
Data availability statement
The original contributions presented in the study are included in the article/Supplementary Material. Further inquiries can be directed to the corresponding author.
Ethics statement
The animal study was approved by the Animal Welfare Committee of the Aquaculture Research Institute of Kindai University. The study was conducted in accordance with the local legislation and institutional requirements (ARIKU-AEC-2022-64).
Author contributions
SS: Data curation, Investigation, Visualization, Writing – original draft, Writing – review & editing. RA: Conceptualization, Investigation, Writing – review & editing. YK: Investigation, Writing – review & editing. MA: Conceptualization, Project administration, Resources, Writing – review & editing. RY: Conceptualization, Project administration, Resources, Writing – review & editing. AT: Conceptualization, Data curation, Funding acquisition, Supervision, Visualization, Writing – original draft, Writing – review & editing.
Funding
The author(s) declare financial support was received for the research, authorship, and/or publication of this article. The authors declare that this study received financial support from Mitsubishi Chemical Corporation. The funding body had no role in the study design, data collection, analysis, interpretation, manuscript writing, or publication decision. Scientific representatives (MA and RY) from Mitsubishi Chemical Corporation contributed to the study design and manuscript preparation. The views expressed are those of the authors alone and do not represent the funder.
Acknowledgments
We would like to express our gratitude to the staff of Amami Station, Aquaculture Research Institute, Kindai University, including Tomoki Matsumasa, Naoto Jin, and Tatsuya Kumada, for their valuable assistance during the experimentation. We also thank Hiroki Sato for his contributions to the laboratory analysis. Additionally, we extend our appreciation to Professor Dr. Mitsuru Eguchi, Faculty of Agriculture, Kindai University, for his insightful comments. We are equally grateful to the reviewers for their constructive feedback and thoughtful suggestions, which significantly improved the manuscript. Finally, we thank Editage (www.editage.com) for providing professional English editing services.
Conflict of interest
MA and RY were employed by the Mitsubishi Chemical Corporation. The funders had no role in study design, data collection and analysis, decision to publish, or preparation of the manuscript.
All the authors declare that the research was conducted in the absence of any commercial or financial relationships that could be construed as a potential conflict of interest.
Publisher’s note
All claims expressed in this article are solely those of the authors and do not necessarily represent those of their affiliated organizations, or those of the publisher, the editors and the reviewers. Any product that may be evaluated in this article, or claim that may be made by its manufacturer, is not guaranteed or endorsed by the publisher.
Supplementary material
The Supplementary Material for this article can be found online at: https://www.frontiersin.org/articles/10.3389/faquc.2024.1450537/full#supplementary-material
References
1
Aida M. Togawa N. Mizuyama K. Aoki Y. Suehiro S. Sakamoto A. et al . (2024). Heyndrickxia coagulans strain SANK70258 suppresses symptoms of upper respiratory tract infection via immune modulation: a randomized, double-blind, placebo-controlled, parallel-group, comparative study. Front. Immunol.15. doi: 10.3389/fimmu.2024.1389920
2
Aida M. Yamada R. Matsuo T. Taniguchi I. Nakamura S.-I. Tsukahara T. (2023). Dietary Weizmannia coagulans strain SANK70258 ameliorates coccidial symptoms and improves intestinal barrier functions of broilers by modulating the intestinal immunity and the gut microbiota. Pathogens12, 96. doi: 10.3390/pathogens12010096
3
Aida M. Yamada R. Nakamura S.-I. Imaoka T. Shimonishi H. Matsuo T. et al . (2022). The effect of supplementation with Weizmannia coagulans strain SANK70258 to coccidia-infected broilers is similar to that of a coccidiostat administration. Vet. Sci.9, 406. doi: 10.3390/vetsci9080406
4
Audy J. Labrie S. Roy D. LaPointe G. (2010). Sugar source modulates exopolysaccharide biosynthesis in Bifidobacterium longum subsp. longum CRC 002. Microbiol.156, 653–664. doi: 10.1099/mic.0.033720-0
5
Bharathi Rathinam R. Tripathi G. Das B. K. Jain R. Acharya A. (2024). Comparative analysis of gut microbiome in Pangasionodon hypopthalmus and Labeo catla during health and disease. Int. Microbiol. 27, 1557–1571. doi: 10.1007/s10123-024-00494-x
6
Birchenough G. M. H. Johansson M. E. Gustafsson J. K. Bergström J. H. Hansson G. C. (2015). New developments in goblet cell mucus secretion and function. Mucosal Immunol.8, 712–719. doi: 10.1038/mi.2015.32
7
Butt R. L. Volkoff H. (2019). Gut microbiota and energy homeostasis in fish. Front. Endocrinol.10. doi: 10.3389/fendo.2019.00009
8
Cerezuela R. Fumanal M. Tapia-Paniagua S. T. Meseguer J. Moriñigo M.Á. Esteban M.Á. (2013). Changes in intestinal morphology and microbiota caused by dietary administration of inulin and Bacillus subtilis in gilthead sea bream (Sparus aurata L.) specimens. Fish Shellfish Immunol.34, 1063–1070. doi: 10.1016/j.fsi.2013.01.015
9
Das S. Ward L. R. Burke C. (2008). Prospects of using marine actinobacteria as probiotics in aquaculture. Appl. Microbiol. Biotechnol.81, 419–429. doi: 10.1007/s00253-008-1731-8
10
Dawood M. A. O. Koshio S. Ishikawa M. Yokoyama S. El Basuini M. F. Hossain M. S. et al . (2016). Effects of dietary supplementation of Lactobacillus rhamnosus or/and Lactococcus lactis on the growth, gut microbiota and immune responses of red sea bream, Pagrus major. Fish Shellfish Immunol.49, 275–285. doi: 10.1016/j.fsi.2015.12.047
11
De Angelis M. Gobbetti M. (2004). Environmental stress responses in Lactobacillus: A review. Proteomics4, 106–122. doi: 10.1002/pmic.200300497
12
Deguara S. Jauncey K. Agius C. (2003). Enzyme activities and pH variations in the digestive tract of gilthead sea bream. J. Fish Biol.62, 1033–1043. doi: 10.1046/j.1095-8649.2003.00094.x
13
Duncan S. H. Louis P. Flint H. J. (2004). Lactate-utilizing bacteria, isolated from human feces, that produce butyrate as a major fermentation product. Appl. Environ. Microbiol.70, 5810–5817. doi: 10.1128/AEM.70.10.5810-5817.2004
14
El-Saadony M. T. Alagawany M. Patra A. K. Kar I. Tiwari R. Dawood M. A. O. et al . (2021). The functionality of probiotics in aquaculture: An overview. Fish Shellfish Immunol.117, 36–52. doi: 10.1016/j.fsi.2021.07.007
15
Esquivel-Elizondo S. Ilhan Z. E. Garcia-Peña E. I. Krajmalnik-Brown R. (2017). Insights into butyrate production in a controlled fermentation system via gene predictions. mSystems2, e00051–17. doi: 10.1128/msystems.00051-17
16
Ikeda Y. Ito N. Yamashita N. Minamikawa N. Nagata K. Yashiro T. et al . (2023). Immunostimulatory effects of Bacillus coagulans SANK70258. bioRxiv. doi: 10.1101/2023.02.21.529342
17
Jeong K.-S. Takeuchi T. Watanabe T. (1991). Improvement of nutritional quality of carbohydrate ingredients by extrusion process in diets of red sea bream. Nippon Suisan Gakkaishi57, 1543–1549. doi: 10.2331/suisan.57.1543
18
Kassambara A. Kosinski M. Biecek P. Fabian S. (2021). survminer: Drawing Survival Curves using ‘ggplot2’. R Package version 0.49, 2021. Available at: https://cran.r-project.org/web/packages/survminer/.
19
Kim D. Beck B. R. Heo S.-B. Kim J. Kim H. D. Lee S.-M. et al . (2013). Lactococcus lactis BFE920 activates the innate immune system of olive flounder (Paralichthys olivaceus), resulting in protection against Streptococcus iniae infection and enhancing feed efficiency and weight gain in large-scale field studies. Fish Shellfish Immunol.35, 1585–1590. doi: 10.1016/j.fsi.2013.09.008
20
Li Z. Bao N. Ren T. Han Y. Jiang Z. Bai Z. et al . (2019). The effect of a multi-strain probiotic on growth performance, non-specific immune response, and intestinal health of juvenile turbot, Scophthalmus maximus L. Fish Physiol. Biochem.45, 1393–1407. doi: 10.1007/s10695-019-00635-4
21
Liu Q. Yu Z. Tian F. Zhao J. Zhang H. Zhai Q. et al . (2020). Surface components and metabolites of probiotics for regulation of intestinal epithelial barrier. Microb. Cell Fact19, 23. doi: 10.1186/s12934-020-1289-4
22
Midhun S. J. Neethu S. Vysakh A. Radhakrishnan E. K. Jyothis M. (2018). Antagonism against fish pathogens by cellular components/preparations of Bacillus coagulans (MTCC-9872) and it’s in vitro probiotic characterisation. Curr. Microbiol.75, 1174–1181. doi: 10.1007/s00284-018-1506-0
23
Morita N. Umemoto E. Fujita S. Hayashi A. Kikuta J. Kimura I. et al . (2019). GPR31-dependent dendrite protrusion of intestinal CX3CR1+ cells by bacterial metabolites. Nature566, 110–114. doi: 10.1038/s41586-019-0884-1
24
Oda K. Murao S. (1974). Purification and some enzymatic properties of acid protease A and B of Scytalidium lignicolum ATCC 24568. Agric. Biol. Chem.38, 2435–2444. doi: 10.1080/00021369.1974.10861522
25
Pan C.-Y. Wang Y.-D. Chen J.-Y. (2013). Immunomodulatory effects of dietary Bacillus coagulans in grouper (Epinephelus coioides) and zebrafish (Danio rerio) infected with Vibrio vulnificus. Aquac. Int.21, 1155–1168. doi: 10.1007/s10499-012-9619-0
26
Ramos M. A. Batista S. Pires M. A. Silva A. P. Pereira L. F. Saavedra M. J. et al . (2017). Dietary probiotic supplementation improves growth and the intestinal morphology of Nile tilapia. Animal11, 1259–1269. doi: 10.1017/S1751731116002792
27
Ramos M. A. Gonçalves J. F. M. Batista S. Costas B. Pires M. A. Rema P. et al . (2015). Growth, immune responses and intestinal morphology of rainbow trout (Oncorhynchus mykiss) supplemented with commercial probiotics. Fish Shellfish Immunol.45, 19–26. doi: 10.1016/j.fsi.2015.04.001
28
Ringø E. Olsen R. E. Gifstad T.Ø. Dalmo R. A. Amlund H. Hemre G.-I. et al . (2010). Prebiotics in aquaculture: a review. Aquac. Nutr.16, 117–136. doi: 10.1111/j.1365-2095.2009.00731.x
29
Sasaki K. Sasaki D. Inoue J. Hoshi N. Maeda T. Yamada R. et al . (2020). Bacillus coagulans SANK 70258 suppresses Enterobacteriaceae in the microbiota of ulcerative colitis in vitro and enhances butyrogenesis in healthy microbiota. Appl. Microbiol. Biotechnol.104, 3859–3867. doi: 10.1007/s00253-020-10506-1
30
Semwal A. Kumar A. Kumar N. (2023). A review on pathogenicity of Aeromonas hydrophila and their mitigation through medicinal herbs in aquaculture. Heliyon9, e14088. doi: 10.1016/j.heliyon.2023.e14088
31
Taniguchi A. Aoki R. Inoue I. Eguchi M. (2022). Succession of the intestinal bacterial community in Pacific bluefin tuna (Thunnus orientalis) larvae. PloS One17, e0275211. doi: 10.1371/journal.pone.0275211
32
Team, R. C (2022). R: A language and environment for statistical computing (Vienna, Austria: R Foundation for Statistical Computing). Available at: https://www.R-project.org/.
33
Therneau T. (2023). A Package for Survival Analysis in R. 5–7, R Package Version 3. Available at: https://cran.r-project.org/web/packages/survival/.
34
Wang Y. (2011). Use of probiotics Bacillus coagulans, Rhodopseudomonas palustris and Lactobacillus acidophilus as growth promoters in grass carp (Ctenopharyngodon idella) fingerlings. Aquac. Nutr.17, e372–e378. doi: 10.1111/j.1365-2095.2010.00771.x
35
Wang Y. Ren Z. Fu L. Su X. (2016). Two highly adhesive lactic acid bacteria strains are protective in zebrafish infected with Aeromonas hydrophila by evocation of gut mucosal immunity. J. Appl. Microbiol.120, 441–451. doi: 10.1111/jam.13002
36
Xiao Z. Storms R. Tsang A. (2006). A quantitative starch–iodine method for measuring alpha-amylase and glucoamylase activities. Anal. Biochem.351, 146–148. doi: 10.1016/j.ab.2006.01.036
37
Xie S. Zhang H. Matjeke R. S. Zhao J. Yu Q. (2022). Bacillus coagulans protect against Salmonella enteritidis-induced intestinal mucosal damage in young chickens by inducing the differentiation of goblet cells. Poult. Sci.101, 101639. doi: 10.1016/j.psj.2021.101639
38
Xu Y. Wang Y. Lin J. (2014). Use of Bacillus coagulans as a dietary probiotic for the common carp, Cyprinus carpio. JWAS45, 403–411. doi: 10.1111/jwas.12139
39
Yu Y. Lv F. Wang C. Wang A. Zhao W. Yang W. (2016). Effects of Bacillus coagulans on growth performance, disease resistance, and HSP70 gene expression in juvenile gibel carp, Carassius auratus gibelio. JWAS47, 729–740. doi: 10.1111/jwas.12308
40
Zhang S. Li P. Lee S. Wang Y. Tan C. Shang N. (2024). Weizmannia coagulans: an ideal probiotic for gut health. Food Sci. Hum. Well.13, 16–26. doi: 10.26599/FSHW.2022.9250002
41
Zhang Z. Yang Q. Liu H. Jin J. Yang Y. Zhu X. et al . (2024). Potential functions of the gut microbiome and modulation strategies for improving aquatic animal growth. Rev. Aquac. 0, 1–18. doi: 10.1111/raq.12959
42
Zhao C. Guo G. Li Z. Chen J. Ren Y. (2023). Effects of probiotics (Bacillus coagulans) supplementation after antibiotic administration on growth, immunity, and intestinal microflora in turbot Scophthalmus maximus. Aquac. Int. 32, 1473–1491. doi: 10.1007/s10499-023-01225-1
Summary
Keywords
goblet cell, Heyndrickxia coagulans , probiotics, red sea bream, spore-forming bacteria
Citation
Shirakashi S, Aoki R, Kobayashi Y, Aida M, Yamada R and Taniguchi A (2024) Exploring spore-forming lactic acid bacterium Heyndrickxia coagulans SANK70258 as a promising probiotic for red sea bream (Pagrus major). Front. Aquac. 3:1450537. doi: 10.3389/faquc.2024.1450537
Received
17 June 2024
Accepted
29 October 2024
Published
22 November 2024
Volume
3 - 2024
Edited by
Parisa Norouzitallab, Swedish University of Agricultural Sciences, Sweden
Reviewed by
Neelesh Kumar, Rani Lakshmi Bai Central Agricultural University, India
Gayatri Tripathi, Central Institute of Fisheries Education (ICAR), India
Federico Moroni, Spanish National Research Council (CSIC), Spain
Updates
Copyright
© 2024 Shirakashi, Aoki, Kobayashi, Aida, Yamada and Taniguchi.
This is an open-access article distributed under the terms of the Creative Commons Attribution License (CC BY). The use, distribution or reproduction in other forums is permitted, provided the original author(s) and the copyright owner(s) are credited and that the original publication in this journal is cited, in accordance with accepted academic practice. No use, distribution or reproduction is permitted which does not comply with these terms.
*Correspondence: Akito Taniguchi, htrakito@nara.kindai.ac.jp
Disclaimer
All claims expressed in this article are solely those of the authors and do not necessarily represent those of their affiliated organizations, or those of the publisher, the editors and the reviewers. Any product that may be evaluated in this article or claim that may be made by its manufacturer is not guaranteed or endorsed by the publisher.